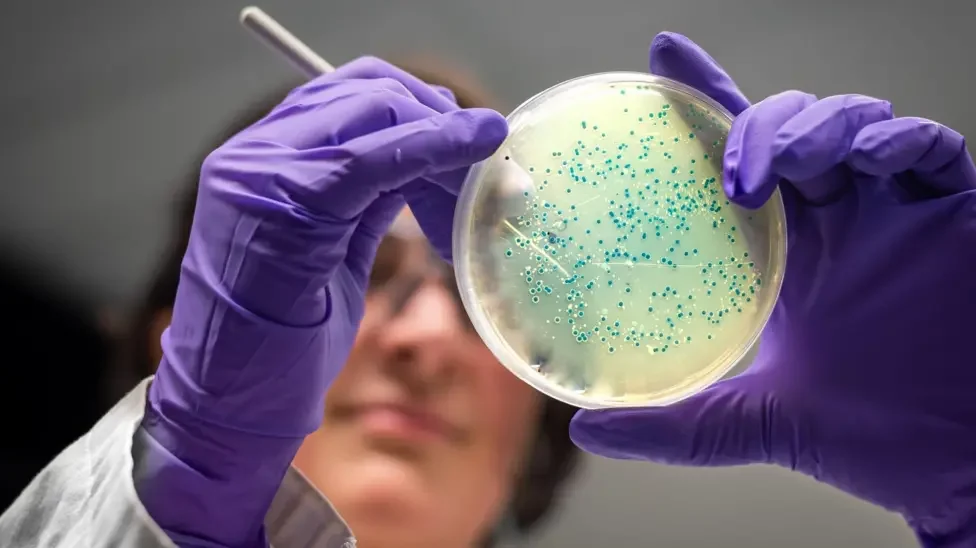

AI’s Resistance Against Resistance
How artificial intelligence is helping scientists design new antibiotics to fight drug-resistant “superbugs” and protect global health.
The Growing Threat of Antibiotic Resistance
Antibiotics transformed medicine in the 20th century. Once-fatal infections like pneumonia, meningitis, and tuberculosis became treatable, and surgical procedures, chemotherapy, and intensive care all became far safer. But over the decades, that success has been quietly eroding. Bacteria have evolved resistance to nearly every class of antibiotic we’ve developed - and the pipeline for new drugs has all but dried up. The World Health Organization now lists antimicrobial resistance (AMR) as one of the top ten global health threats, estimating that it already causes around 1.3 million deaths each year and could claim up to 10 million lives annually by 2050 if left unchecked.
Why New Antibiotics Are Hard to Develop
The problem is two-fold. First, bacteria are extraordinarily good at adapting. Every time an antibiotic is used, a small number of microbes survive and pass on their resistance genes, sometimes even sharing them with other species. Second, developing new antibiotics is slow, expensive, and scientifically challenging. Over the last four decades, the number of truly novel antibiotic classes brought to market has plummeted. Many pharmaceutical companies have moved away from antibiotic research altogether, citing low returns on investment, since new drugs are often reserved for last-resort use to prevent resistance from developing further.
AI Steps In: Designing Drugs from Scratch
This is where artificial intelligence (AI) is starting to offer hope. Rather than relying on traditional trial-and-error screening of millions of chemical compounds - a process that can take years and cost hundreds of millions of pounds - researchers are now training AI models to design entirely new antibiotics from scratch. These systems analyse vast datasets of existing molecules, learn the features that make them effective against bacteria, and then generate novel molecular structures predicted to be both potent and safe.
Recent studies have shown remarkable early success. In 2025, scientists at MIT used generative AI to create tens of millions of potential antibiotic compounds and identified a small group capable of killing some of the most resistant bacteria, including MRSA and drug-resistant gonorrhoea. Similarly, researchers at the University of Pennsylvania developed an AI model that designed new antimicrobial peptides - short chains of amino acids that act like natural antibiotics - with strong activity in laboratory tests. What once took years of laborious screening can now happen in weeks.
Why This Is So Important
The importance of this breakthrough cannot be overstated. Antibiotic resistance threatens to undo a century of medical progress. Without effective antibiotics, even routine operations could become dangerous, childbirth could carry life-threatening risk, and modern cancer therapies that rely on immune suppression could become unfeasible. Infections like urinary tract infections, currently treatable in days, could once again become deadly. The rise of “superbugs” such as carbapenem-resistant Enterobacterales and drug-resistant tuberculosis already demonstrates how fragile our defences are.
How AI Accelerates Discovery
AI radically accelerates the discovery process. By expanding the “chemical space” researchers can explore, AI can uncover molecules that humans might never think to design. It also makes drug development far more efficient by identifying which candidates are worth synthesising and testing in the lab. In a field that has long struggled with declining innovation, this represents a powerful tool for rejuvenating antibiotic research.
Challenges Remain
Of course, challenges remain. Translating an AI-generated molecule into a safe, effective medicine still requires years of laboratory testing, clinical trials, and regulatory approval. Many AI-designed compounds may prove too toxic, unstable, or impractical to manufacture. And even if new antibiotics reach the market, the underlying issue of overuse remains. Without strong antibiotic stewardship - careful prescribing, public education, and global coordination - resistance will inevitably evolve again.
A New Era for Antibiotic Research
Still, the integration of AI into antibiotic discovery offers a much-needed sense of momentum. It bridges the gap between cutting-edge data science and one of medicine’s most urgent challenges: keeping infections treatable in a world of evolving superbugs. While hurdles remain, this technology could be the spark that helps prevent the post-antibiotic era many scientists warn is approaching.